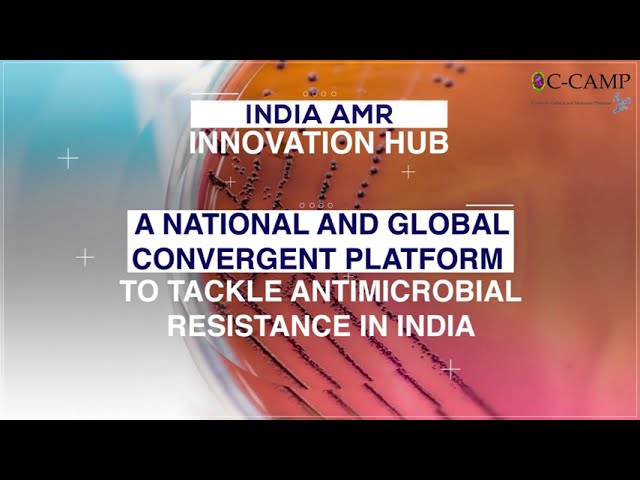
India AMR Innovation Hub announced as Innovation arm of India's AMR NAP 2.0

top of page
AMR Videos
01:22
India AMR Innovation Hub announced as Innovation arm of India's AMR NAP 2.0
As Ministry of Health and Family Welfare, Govt of India took the landmark step of launching India's National Action Plan on Antimicrobial Resistance 2.0- NAP 2.0 CCAMP with India AMR Innovation Hub #IAIH has been declared as the Innovation arm of NAP 2.0 to act as a platform for action to bend the curve of AMR in India, and beyond through deep-science contextual solutions.
C-CAMP anchored and Principal Scientific Adviser to Govt of India (PSA) chaired IAIH enables emerging solutions to tackle this urgent crisis across Human Health, Agri-Animal Health and Environment (One Health) in the Indian context, in the areas of preventatives, therapeutics diagnostics, detection, screening, monitoring, tools for surveillance etc.
Catch Prof A.K. Sood, PSA, Chair of IAIH and Dr Taslimarif Saiyed,
C-CAMP Director-CEO and Vice Chair of IAIH share their vision for IAIH
#IndiaFightsAMR

02:23
AMR Innovator School for Innovators in AMR Diagnostics
The first such school organized by C-CAMP in collaboration with CARB-X for In Vitro Diagnostics development for ESKAPE pathogens. India is an emerging hotspot for diagnostics innovations and this immersive, hands-on training course organized by Dr Taslimarif Saiyed, C-CAMP Dir-CEO and Betsy Trainor, Alliance Director, CARB-X and trainer Peter J. Dailey, FINDDx led the participants into a 3 day deep dive into product development for POCT (point-of-care-testing) and other rapid diagnostics techniques to combat ESKAPE pathogens.

01:34
SBI Foundation & C-CAMP AMR Program
C-CAMP in association with SBI Foundation have launched a program to identify and support innovations in AMR
#innovatorsforBharat #amr #innovation #entrepreneurship #entrepreneur

02:47
India AMR Innovation Hub
India AMR Innovation Hub #IAIH, a CCAMP anchored & Office of Principal Scientific Adviser, GoI chaired global platform is on a mission to fight #AntimicrobialResistance, a global health threat poised to kill 10 million by 2050. IAIH is working with ~40 Global & Indian stakeholders to curtail #AMR with #OneHealth approach. It is enabling an AMR innovation ecosystem that envisions reducing AMR burden in India & beyond through policymaking, stewardship & interventions.
bottom of page


